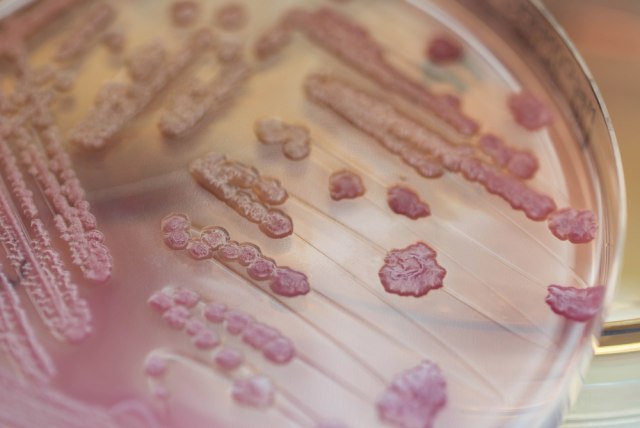

Dobili smo najgoru reprezentaciju na Evropskom prvenstvu
Vaterpolisti Izraela završili su nastup na Evropskom prvenstvu u Beogradu na poslednjem mestu.
14:15
18.1.2026.
2 d
Ponedeljak, 02.05.2022.
13:36
Višegodišnja studija o ulozi crevnih bakterija ešerihija koli u Kronovoj bolesti otkriva da zapaljenje creva oslobađa hemikalije koje neguju rast bakterija i podstiču njihovu sposobnost da izazovu upalu.
Ovo je arhivirana verzija originalne stranice. Izvinjavamo se ukoliko, usled tehničkih ograničenja, stranica i njen sadržaj ne odgovaraju originalnoj verziji.
Predsednik Srbije Aleksandar Vučić govorio je u Davosu o pretnjama i ponašanju opozicije, poručivši da građani Srbije jasno prepoznaju razliku između onih koji rade i onih koji, kako je rekao, nemaju nikakav rezultat iza sebe.
18:08
20.1.2026.
4 min
Rat u Ukrajini – 1.427. dan. U prestonici Ukrajine, najteže pogođenoj nestancima struje, građani mogu dobiti toplu i besplatnu hranu u mobilnim kuhinjama. Predsednik Ukrajine Volodimir Zelenski upozorava da Rusija planira nove masovne napade.
17:55
20.1.2026.
18 min
Portparol Generalštaba Oružanih snaga Irana Abolfazl Šekarči izjavio je danas da će svaka neprijateljska akcija prema ajatolahu Sejedu Aliju Hamneiju, rezultirati razornom vojnom odmazdom.
17:52
20.1.2026.
20 min
Sergej Lavrov iskoristio citat Zorana Milanovića da uporedi Grenland i Krim, dok Milanović naglašava da o Grenlandu odlučuje isključivo grenlandski narod.
17:40
20.1.2026.
32 min
Predsednik Srbije Aleksandar Vučić prokomentarisao je iz Davosa, gde učestvuje na Svetskom ekonomskom forumu, rang-listu Globalnog indeksa vatrene moći za 2025. godinu, po kojem je Vojska Srbije najjače rangirana vojska u regionu.
17:25
20.1.2026.
49 min
Glumac Kifer Saterlend je uhapšen pre nekoliko dana zbog napada na vozača Ubera, a sada su se pojavili novi detalji tog incidenta.
16:33
20.1.2026.
1 h
U Austriji postoji krava koja koristi alat – da se češka. Takvo ponašanje je prvi put naučno dokumentovano kod goveda. U čemu je posebnost Veronike? I da li potcenjujemo te blage životinje?
15:23
20.1.2026.
2 h
Aleksandar Kos priveden je prošle noći u Beogradu, zbog, kako su naveli mediji, korišćenja nedozvoljenih supstanci.
14:56
20.1.2026.
3 h
Zvezda filma Kung fu frka (Kung Fu Hustle), Brus Lung, preminuo je u 77. godini.
14:55
20.1.2026.
3 h
NASA je spremna da lansira Artemis II, najnoviju misiju ka Mesecu, čiji je cilj da pošalje četiri astronauta na desetodnevni let svemirom.
14:33
20.1.2026.
3 h
Zdravo starenje ne dešava se preko noći, već je rezultat malih, promišljenih navika koje s vremenom podržavaju um i telo.
17:05
20.1.2026.
1 h
Rak pluća često se ne otkrije sve dok se ćelije ne prošire po telu, ali postoje i rani znaci koji mogu ukazivati na njegovo prisustvo.
12:11
20.1.2026.
6 h
Ispijanje kafe ima mnogo prednosti – od poboljšanja funkcije mozga i smanjenja upale, do poboljšanja zdravlja srca i metabolizma. Međutim, kafa takođe može da utiče na to kako vaše telo apsorbuje određene suplemente.
9:21
20.1.2026.
8 h
Iako kolonoskopija nikome nije na listi omiljenih aktivnosti, na društvenim mrežama poslednjih nedelja širi se trend u kojem ljudi, odmah nakon zahvata i dugog posta, odlaze pravo u restorane kako bi se počastili "poštenim" obrokom.
7:57
20.1.2026.
10 h
Najbolji čajevi za glavobolje i migrene uključuju čaj od kamilice, čaj od mente, čaj od đumbira, čaj od karanfilića, čaj od kurkume i čaj od lavande.
20:29
19.1.2026.
21 h
HBO i HBO Max su juče objavili seriju "Vitez sedam kraljevstava", novi prednastavak popularne "Igre prestola".
17:40
20.1.2026.
33 min
Gledaoci poslednjih godina sve češće posežu za filmovima koji klasične žanrove okreću u neočekivanom pravcu, nudeći sporiji ritam, snažnu atmosferu i duboku psihološku slojevitost.
16:02
20.1.2026.
2 h
Pevačica Blagica Beti Đorđević, preminula je 80. godini, a tokom karijere pevala je hitove koji se i dan danas pevaju.
13:35
20.1.2026.
4 h
Na današnji dan, 20. januara 2008. godine, prvi put je emitovana dramska serija "Breaking Bad", koja je veoma brzo prikovala milione gledalaca širom sveta za male ekrane.
11:19
20.1.2026.
6 h
Slavna glumica Džodi Foster otkrila je da i dalje ima ožiljke od napada lava koji je pretrpela kao devetogodišnjakinja dok je snimala svoj prvi film.
7:57
20.1.2026.
10 h
Da li ste imali priliku da isprobate 2XKO?
16:40
20.1.2026.
1 h
Makedonac će zameniti kyousukea.
17:26
19.1.2026.
1 d
Singapur je jedna od retkih država koje esport formalno priznaju kao sport u okviru nacionalnog zakona.
17:17
16.1.2026.
4 d
Pare koje u životu nećemo videti…
16:39
15.1.2026.
5 d
Barsa je oformila veoma solidnu ekipu sa iskusnim igračicama.
19:54
14.1.2026.
5 d
Komentari 2
Pogledaj komentare